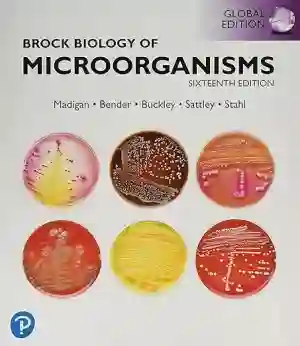
Cover of Brock Biology Of Microorganisms by Michael Madigan, John Martinko, Kelly Bender, Daniel Buckley, David Stahl, Thomas Brock, Paul Dunlap, David Clark, Matthew Sattley

Explore Textbooks Documents
Discover study materials and learning resources connected to popular academic textbooks used in college and university courses.
Textbooks play an important role in academic learning, helping students understand complex topics across subjects such as science, engineering, business, medicine, and the humanities. The CramX textbook resources directory helps students discover study materials related to widely used academic textbooks and course references.
Instead of hosting full textbooks, this page provides access to community-generated learning materials connected to specific books. These resources may include summaries, study guides, notes, practice questions, and supporting explanations that help students better understand the concepts presented in their course textbooks.
Many of these textbooks are commonly used in university courses around the world. Students can explore related programs through our universities directory, browse academic subjects, review helpful study documents and notes, or prepare for exams using the test preparation center.
Browse the textbook resources below to discover study materials connected to popular academic textbooks used in college and university courses.